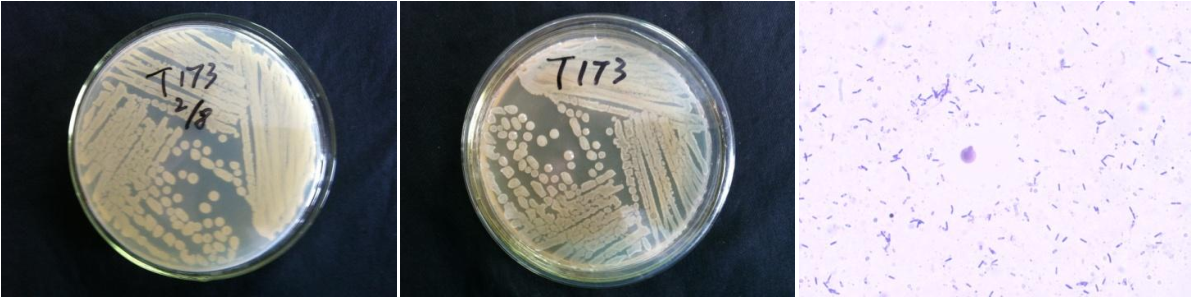

Loading...
| StrainNO | B400 |
| Classification | Bacillus |
| 16s rDNA sequence | GGGCGGGGCTGGGCTCCATAAAGGTTACCTCACCGACTTCGGGTGTTACAAACTCTCGTGGTGTGACGGGCGGTGTGTACAAGG CCCGGGAACGTATTCACCGCGGCATGCTGATCCGCGATTACTAGCGATTCCAGCTTCACGCAGTCGAGTTGCAGACTGCGATCC GAACTGAGAACAGATTTGTGGGATTGGCTTAACCTCGCGGTTTCGCTGCCCTTTGTTCTGTCCATTGTAGCACGTGTGTAGCCC AGGTCATAAGGGGCATGATGATTTGACGTCATCCCCACCTTCCTCCGGTTTGTCACCGGCAGTCACCTTAGAGTGCCCAACTGA ATGCTGGCAACTAAGATCAAGGGTTGCGCTCGTTGCGGGACTTAACCCAACATCTCACGACACGAGCTGACGACAACCATGCAC CACCTGTCACTCTGCCCCCGAAGGGGACGTCCTATCTCTAGGATTGTCAGAGGATGTCAAGACCTGGTAAGGTTCTTCGCGTTG CTTCGAATTAAACCACATGCTCCACCGCTTGTGCGGGCCCCCGTCAATTCCTTTGAGTTTCAGTCTTGCGACCGTACTCCCCAG GCGGAGTGCTTAATGCGTTAGCTGCAGCACTAAGGGGCGGAAACCCCCTAACACTTAGCACTCATCGTTTACGGCGTGGACTAC CAGGGTATCTAATCCTGTTCGCTCCCCACGCTTTCGCTCCTCAGCGTCAGTTACAGACCAGAGAGTCGCCTTCGCCACTGGTGT TCCTCCACATCTCTACGCATTTCACCGCTACACGTGGAATTCCACTCTCCTCTTCTGCACTCAAGTTCCCCAGTTTCCAATGAC CCTCCCCGGTTGAGCCGGGGGCTTTCACATCAGACTTAAGGAACCGCCTGCGAGCCCTTTACGCCCAATAATTCCGGACAACGC TTGCCACCTACGTATTACCGCGGCTGCTGGCACGTAGTTAGCCGTGGCTTTCTGGTTAGGTACCGTCAAGGTACCGCCCTATTCGAACGGTACTTGTTCTTCCCTAACAACAGAGCTTTACGATCCGAAAACCTTCATCACTCACGCGGCGTTGCTCCGTCAGACTTT CGTCCATTGCGGAAGATTCCCTACTGCTGCCTCCCGTAGGAGTCTGGGCCGTGTCTCAGTCCCAGTGTGGCCGATCACCCTCTC AGGTCGGCTACGCATCGTTGCCTTGGTGAGCCATTACCTCACCAACTAGCTAATGCGCCGCGGGTCCATCTGTAAGTGGTAGCC GAAGCCACCTTTTATGTTTGAACCATGCGGTTCAAACAAGCATCCGGTATTAGCCCCGGTTTCCCGGAGTTATCCCAGTCTTAC AGGCAGGTTACCCACGTGTTACTCACCCGTCCGCCGCTAACAGGGAGCAAGCTCCCATCTTCCGCTCGACTGCATGTATAG CACGCCCGCCCGC |
| Strain Morphology Photos | |
| Morphological Description | round;lychee white;steamed bun shaped;edge neatly;bright;sticky;waxy;Rod;having spore;spore mesophytic |